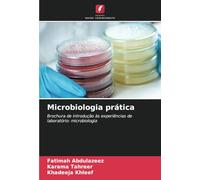

- 1
- 2
- 3
- 4
- 5
- pagina successiva
🤖 Chiedi a ChatGPT
Informazioni su "laboratorio di microbiologia,"
Dopo la ricerca per il prezzi più economico, 778 offerte sono state trovate.
Sono stati trovati molti prodotti in 46 categorie con un fascia di prezzo a partire da 4,47 € a 1.790,82 €.
I dati relativi "laboratorio di microbiologia,"
- Nel complesso, la nostra ricerca ha mostrato 7 differenti web-shop per il tuo prodotto "laboratorio di microbiologia,", incluso amazon-marketplace.it, Amazon.it, lafeltrinelli.it e ibs.it.
- Nel caso in cui preferissi un articolo da un particolare marche, puoi trovare 14 web-shop per questo prodotto. Se non hai ancora preso una decisione, puoi anche filtrare i tuoi favoriti costruttori e scegliere tra 14 produttori.
- 14 differenti marche offrono il prodotto - Levenhuk, Zanichelli, Hoepli e Amosfun, che stavi cercando.
- Inoltre, altri utenti hanno mostrato interesse verso il seguente prodotto: .
- Personalizza i tuo prodotti scegliendo uno dei 26 colorazioni.